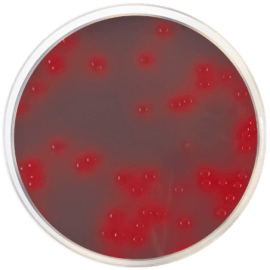
main product photo

Close
CLED AGAR WITH ANDRADE´S INDICATOR 500 grams/bottle
SKU
CDL/1303
Brand
CONDALAB
Pre-order (Deliver in 8 to 12 weeks)
CLED Agar with Andrade's Indicator is a non-selective solid medium for the cultivation of pathogens from urine specimens. It has a composition similar to CLED Agar, but with Andrades indicator added. It is based on the principle of lactose fermentation, lowering the pH of the medium with acid production. It improves colony detection and microorganism identification by the addition of the acid fuchsin, which differentiates between lactose fermenting and non-lactose fermenting bacteria.
Beef extract, Casein peptone and Gelatin peptone provide nitrogen, vitamins, minerals and amino acids essential for growth; Lactose is the fermentable carbohydrate providing carbon and energy; L-Cystine is added as a growth supplement for cystine-dependent coliforms. Differentiation of lactose-fermenters and lactose non-fermenters is achieved using bromothymol blue and Andrades indicator as pH indicators. Bacteriological Agar is the solidifying agent
Characteristics of the colonies:
- Escherichia coli: bright pink, semi- translucent colonies with surrounding pink halo.
- Proteus mirabilis: blue-green, translucent colonies.
- Staphylococcus aureus: smooth, entire, opaque bright golden yellow colonies. Lactose fermenting.
CLED Agar with Andrade's Indicator is a non-selective solid medium for the cultivation of pathogens from urine specimens. It has a composition similar to CLED Agar, but with Andrades indicator added. It is based on the principle of lactose fermentation, lowering the pH of the medium with acid production. It improves colony detection and microorganism identification by the addition of the acid fuchsin, which differentiates between lactose fermenting and non-lactose fermenting bacteria.
Beef extract, Casein peptone and Gelatin peptone provide nitrogen, vitamins, minerals and amino acids essential for growth; Lactose is the fermentable carbohydrate providing carbon and energy; L-Cystine is added as a growth supplement for cystine-dependent coliforms. Differentiation of lactose-fermenters and lactose non-fermenters is achieved using bromothymol blue and Andrades indicator as pH indicators. Bacteriological Agar is the solidifying agent
Characteristics of the colonies:
- Escherichia coli: bright pink, semi- translucent colonies with surrounding pink halo.
- Proteus mirabilis: blue-green, translucent colonies.
- Staphylococcus aureus: smooth, entire, opaque bright golden yellow colonies. Lactose fermenting.
| Brand | CONDALAB |
|---|
Write Your Own Review

Validate your login